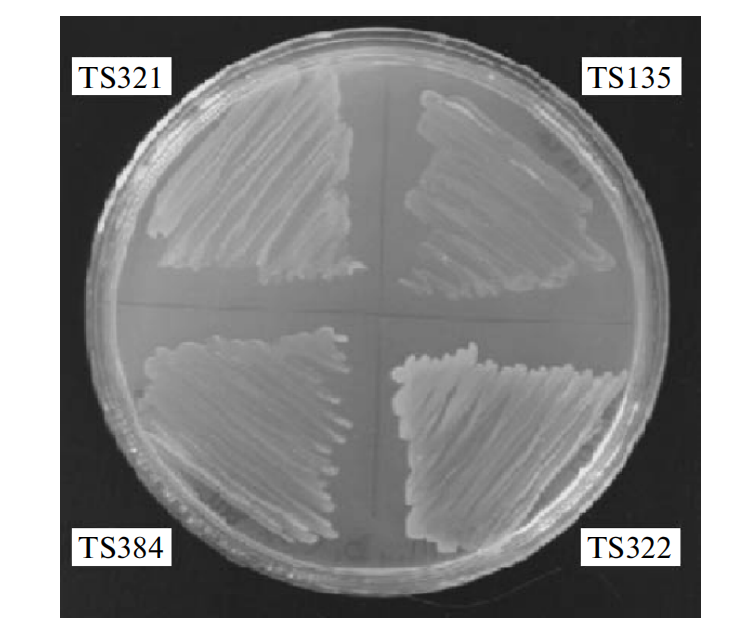
172258249212070567.png 图片1.png

通过缺失突变ΔfadR ΔaceF和诱导突变adhE adhR atoC,引入aceF+,为atoB添加启动子Ptet,改变了大肠杆菌的合成途径,增加了丁酸产量。

参考文献:Seregina, T.A., Shakulov, R.S., Debabov, V.G. et al. Construction of a butyrate-producing E. coli strain without the use of heterologous genes. Appl Biochem Microbiol 46, 745–754 (2010).
通过缺失突变ΔfadR ΔaceF和诱导突变adhE adhR atoC,引入aceF+,为atoB添加启动子Ptet,改变了大肠杆菌的合成途径,增加了丁酸产量。
参考文献:Seregina, T.A., Shakulov, R.S., Debabov, V.G. et al. Construction of a butyrate-producing E. coli strain without the use of heterologous genes. Appl Biochem Microbiol 46, 745–754 (2010).